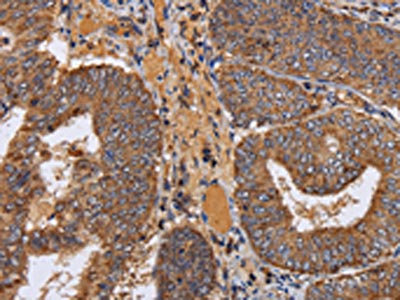

NDUFA1 Antibody
-
中文名稱:NDUFA1兔多克隆抗體
-
貨號:CSB-PA220820
-
規(guī)格:¥1100
-
圖片:
-
The image on the left is immunohistochemistry of paraffin-embedded Human thyroid cancer tissue using CSB-PA220820(NDUFA1 Antibody) at dilution 1/70, on the right is treated with fusion protein. (Original magnification: ×200)
-
The image on the left is immunohistochemistry of paraffin-embedded Human colon cancer tissue using CSB-PA220820(NDUFA1 Antibody) at dilution 1/70, on the right is treated with fusion protein. (Original magnification: ×200)
-
Gel: 10%SDS-PAGE, Lysate: 40 μg, Lane: Hela cells, Primary antibody: CSB-PA220820(NDUFA1 Antibody) at dilution 1/400, Secondary antibody: Goat anti rabbit IgG at 1/8000 dilution, Exposure time: 10 seconds
-
-
其他:
產(chǎn)品詳情
-
Uniprot No.:
-
基因名:
-
別名:NDUFA1; NADH dehydrogenase [ubiquinone] 1 alpha subcomplex subunit 1; Complex I-MWFE; CI-MWFE; NADH-ubiquinone oxidoreductase MWFE subunit
-
宿主:Rabbit
-
反應種屬:Human
-
免疫原:Fusion protein of Human NDUFA1
-
免疫原種屬:Homo sapiens (Human)
-
標記方式:Non-conjugated
-
抗體亞型:IgG
-
純化方式:Antigen affinity purification
-
濃度:It differs from different batches. Please contact us to confirm it.
-
保存緩沖液:-20°C, pH7.4 PBS, 0.05% NaN3, 40% Glycerol
-
產(chǎn)品提供形式:Liquid
-
應用范圍:ELISA,WB,IHC
-
推薦稀釋比:
Application Recommended Dilution ELISA 1:2000-1:5000 WB 1:500-1:2000 IHC 1:100-1:300 -
Protocols:
-
儲存條件:Upon receipt, store at -20°C or -80°C. Avoid repeated freeze.
-
貨期:Basically, we can dispatch the products out in 1-3 working days after receiving your orders. Delivery time maybe differs from different purchasing way or location, please kindly consult your local distributors for specific delivery time.
-
用途:For Research Use Only. Not for use in diagnostic or therapeutic procedures.
相關產(chǎn)品
靶點詳情
-
功能:Accessory subunit of the mitochondrial membrane respiratory chain NADH dehydrogenase (Complex I), that is believed not to be involved in catalysis. Complex I functions in the transfer of electrons from NADH to the respiratory chain. The immediate electron acceptor for the enzyme is believed to be ubiquinone.
-
基因功能參考文獻:
- Results from a study on gene expression variability markers in early-stage human embryos shows that NDUF1A is a putative expression variability marker for the 3-day, 8-cell embryo stage. PMID: 26288249
- The gene signature of OPA1, CTSA, NDUFA1, STK10 and PRDX1 was able to identify patients post-implant with a sensitivity of 91% and a specificity of 86% in discrimination between post-implant group and healthy controls. PMID: 27177495
- Fanconi anemia complementation group A mutants show defective respiration through Complex I, diminished ATP production and metabolic sufferance with an increased AMP/ATP ratio. PMID: 23791750
- Heterozygous mutation in the X chromosomal NDUFA1 gene in a girl with complex I deficiency PMID: 21596602
- Mutations in the NDUFA1 gene is linked to a delayed mitochondrial network recovery in OXPHOS disorders. PMID: 20153825
- Species-specific and mutant MWFE proteins effect on the assembly of a functional mammalian mitochondrial complex I. PMID: 11937507
- A family-based association study finds that the NDUFA1 gene is unlikely to harbor a major visual loss susceptibility locus for Leber hereditary optic neuropathy. PMID: 12084895
- Oxidative stress and partial deficiencies of mitochondrial complex I are key factors in the pathogenesis of Parkinson's disease. (REVIEW) PMID: 15038604
- Suppression of NDUFA1 expression could represent a key pathogenic mechanism in the development of basal cell carcinoma PMID: 15854127
- Two novel p.Gly8Arg and p.Arg37Ser hemizygous mutations in NDUFA1 were identified in two unrelated male patients presenting with Leigh's syndrome and with myoclonic epilepsy and developmental delay. PMID: 17262856
- hypothesize that the novel G32R mutation in NDUFA1 is causing complex I deficiency either by itself or in synergy with additional mtDNA variants PMID: 19185523
顯示更多
收起更多
-
相關疾病:Mitochondrial complex I deficiency (MT-C1D)
-
亞細胞定位:Mitochondrion inner membrane; Single-pass membrane protein; Matrix side.
-
蛋白家族:Complex I NDUFA1 subunit family
-
組織特異性:Primarily expressed in heart and skeletal muscle.
-
數(shù)據(jù)庫鏈接:
Most popular with customers
-
-
YWHAB Recombinant Monoclonal Antibody
Applications: ELISA, WB, IHC, IF, FC
Species Reactivity: Human, Mouse, Rat
-
Phospho-YAP1 (S127) Recombinant Monoclonal Antibody
Applications: ELISA, WB, IHC
Species Reactivity: Human
-
-
-
-
-